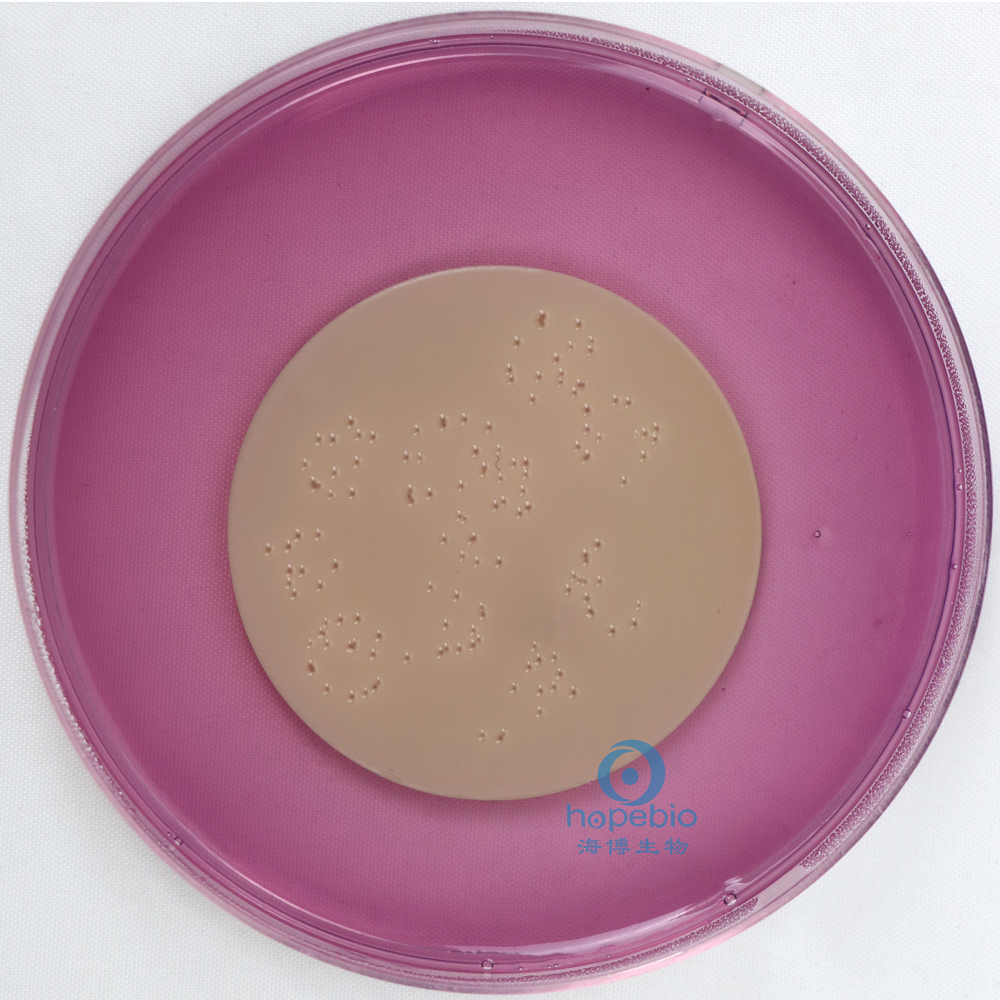
产品细节图片2

万千商家帮你免费找货
0 人在求购买到急需产品
- 详细信息
- 文献和实验
- 技术资料
- 英文名:
MFC Agar
- 保质期:
三年
- 供应商:
青岛海博生物
- 规格:
250g
成分(g/L):
| 多价蛋白胨 | 5.0g |
| 胰蛋白胨 | 10.0g |
| 乳糖 | 12.5g |
| 酵母粉 | 3.0g |
| 三号胆盐 | 1.5g |
| 氯化钠 | 5.0g |
| 苯胺蓝 | 0.2g |
| 琼脂 | 15.0g |
| 玫红酸 | 0.1g |
| PH值 | 7.4±0.2 |
检验原理:
胰胨、多胨和酵母膏粉提供氮源、维生素和生长因子;氯化钠维持均衡的渗透压;乳糖为可发酵糖类;3 号胆盐抑制革兰氏阳性菌;琼脂是培养基的凝固剂;玫红酸和苯胺蓝为pH 指示剂。
粪大肠菌群可在44.5℃条件下分解乳糖产酸,使培养基pH下降,菌落为亮蓝色,其他不发酵乳糖的肠道菌菌落为无色、灰色或淡红色。
用 法:
称取本品52.3克,加热煮沸溶解于1000ml蒸馏水中,冷却至45-50℃时,倾入无菌平皿。无需高压灭菌。
培养基的加热灭菌操作视频:http://www.hopebiol.com/video/jiaremiejun.asp
不同细菌在MFC琼脂上的生长特征:
![]() |
![]() |
|||
| 大肠埃希氏菌 蓝色菌落 |
鼠伤寒沙门氏菌 无色菌落 |
MFC琼脂微生物灵敏度试验:
按标签用法制备培养基,接种以下质控菌株,放置44.5℃需氧培养24±2小时。
注:回收率计算时,用TSA琼脂做对照培养基。

MFC琼脂培养基原理及使用方法:http://www.hopebiol.com/asphtml/refere10385.htm
风险提示:丁香通仅作为第三方平台,为商家信息发布提供平台空间。用户咨询产品时请注意保护个人信息及财产安全,合理判断,谨慎选购商品,商家和用户对交易行为负责。对于医疗器械类产品,请先查证核实企业经营资质和医疗器械产品注册证情况。
文献和实验用 途: 用于水中粪大肠菌群的滤膜法测定(2006年生活饮用水卫生规范)。 原 理: 胰胨、多胨和酵母膏粉提供氮源、维生素和生长因子;氯化钠维持均衡的渗透压;乳糖为可发酵糖类;3号胆盐抑制革兰氏阳性菌;琼脂
做生物实验的人对琼脂和琼脂糖一定都不会陌生。不过要让你说出它们两者的区别,我想不少人都会支支吾吾。反正不一样呗,培养基用的是琼脂粉,电泳用的是琼脂糖。具体有啥学问,听我一一道来。 先来说说琼脂,它的英文名为agar。这个词来源于马来语的agar-agar,意思是胶状物。中国人亦称为洋菜或冻粉。日本人称之为寒天(kanten),因为它在冬天收获。台湾人叫它菜燕,和燕窝的质感差不多。韩国人的叫法是한
也称“琼胶”、“冻粉”。是从石花菜、江蓠等红藻植物提制的多糖。其主要成分为多聚半乳糖的硫酸脂。制成的商品有的为条状,有的为粉状。琼脂的最有用特性是它的凝点和熔点之间的温度相差很大。它在水中需加热至95℃时才开始熔化,熔化后的溶液温度需降到 40℃时才开始凝固,所以它是配制固体培养基的最好凝固剂。用琼脂配制的固体培养基,可用以进行高温培养而不熔化,在凝固之前接种时,也不致将培养物烫死。因此,琼脂是制备各种生物培养基中应用最广泛的一种凝固剂。琼脂的浓度,通常是液体培养基的 1~ 1.5%
技术资料暂无技术资料 索取技术资料